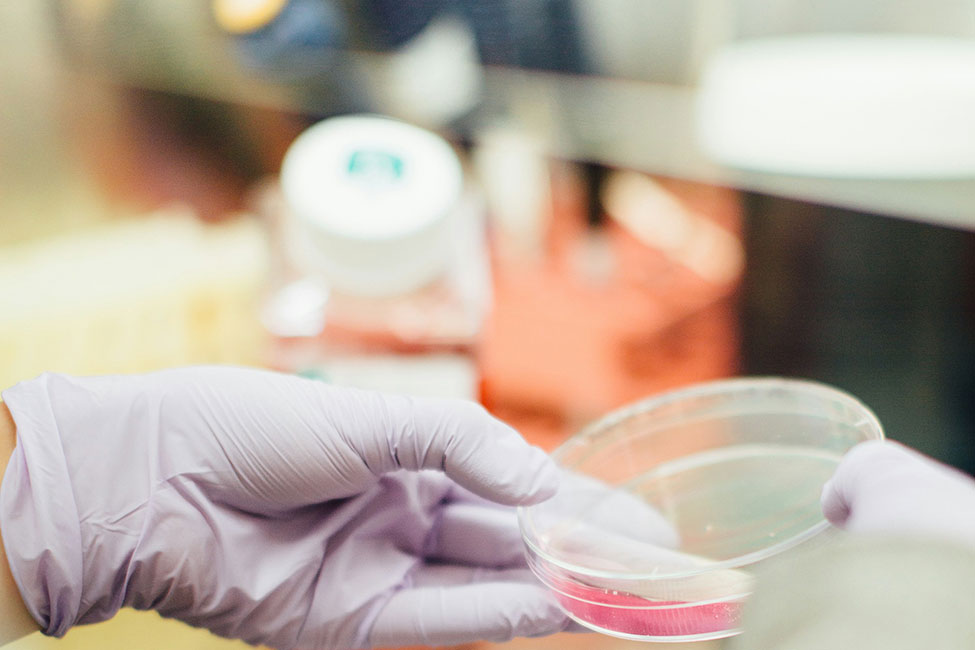

Products
Equip your laboratory for peak performance with Copan's unmatched, expertly engineered sample collection and transport devices and laboratory essentials
Explore Products
Laboratory Automation & AI
Unlock new levels of efficiency with Copan's transformative automation and AI innovations. Experience how our customized solutions support your team so you can focus on what matters most.
Learn More
Scientific Studies
Explore our full library of scientific studies documenting the proven performance of our innovative collection devices, automation, and AI across diverse applications and workflows.
Learn MoreWelcome to Innomed Diagnostics

Our Foundation:
The Strength of Partnership

Our Mission:
Empowering Diagnostic in India

Our Vision:
Shaping the Future of diagnostic
Why Innomed
Why Choose Innomed Diagnostics Pvt Ltd?
About Us
As a proud member of Vision Groups Holding, Innomed
Diagnostic Pvt Ltd is honoured to be the exclusive strategic
partner for Copan in India.
This powerful alliance brings together Vision Groups' deep
understanding of the Indian healthcare landscape with Copan
Group's globally renowned expertise in high-quality sample
collection products and cutting-edge automated workflow
solutions.

Trending Application Fields
Explore our solutions starting from trending topics.
Why Choose Us
Discover the Innomed Difference
Explore our cutting-edge solutions and join us in revolutionizing diagnostics across India. Partner with Innomed Diagnostics Pvt Ltd to elevate your capabilities and contribute to a healthier future.
Discover Our SolutionsLet's Connect
Have questions or ideas? Reach out and let's start a meaningful conversation.
Get in TouchAdvancing Diagnostics in India
Use our search tool to quickly find the information you're looking for and get solution.
Know More












